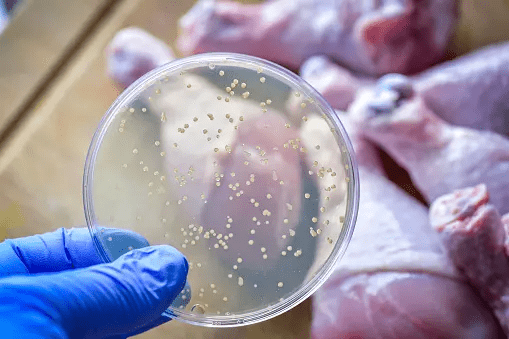

خبرني - السالمونيلا هي عائلة من البكتيريا المعوية تضم أكثر من 2000 صنف، حيث يُعتبر أكثر من 200 صنفًا منها مُسببًا للأمراض لدى البشر، مما يمكن أن يؤدي إلى حدوث عدوات ثانوية.
كما أنها جنس من البكتيريا المعوية، تتبع العائلة السالمونيلا سبارتا، وتُعرف بأنها بكتيريا عصوية سالبة لصبغة جرام، وتعيش في البيئات اللاهوائية، وتتمتع بالقدرة على الحركة.
ينقسم جنس السالمونيلا إلى عدة أنواع، منها السالمونيلا التيفية (Salmonella Typhi) والسالمونيلا غير التيفية (Non-Typhoidal Salmonella).
الأسباب المحتملة للإصابة بالسالمونيلا:
– تلوث الخضراوات والفواكه بالبكتيريا.
– تلوث الغذاء بالبراز البشري المُصاب.
– انتقال البكتيريا من شخص مُصاب إلى آخرين عبر اليدين الملوثتين بالبراز.
– وجود السالمونيلا في الزواحف والقوارض.
علاج الإصابة بالسالمونيلا:
غالبًا ما تختفي الأعراض من تلقاء نفسها خلال عدة أيام دون الحاجة لتناول أي دواء. ومع ذلك، يجب على المُصاب تعويض السوائل التي فقدها بسبب الإسهال والقيء لتجنب الجفاف.
في بعض الحالات، يُمكن توجيه العلاج الطبي وفقًا للحالة، وقد يتضمن ذلك:
– معالجة الإسهال باستخدام محاليل تحتوي على أملاح وسكر عن طريق الفم أو عبر الوريد.
– استخدام المضادات الحيوية للحالات الحادة، لكنها لا تقلل من مدة الإسهال.
– معالجة الأشخاص الذين يعانون من أمراض مزمنة أو الذين انتشر التلوث لديهم في الدم أو في أماكن أخرى خارج الجهاز الهضمي.